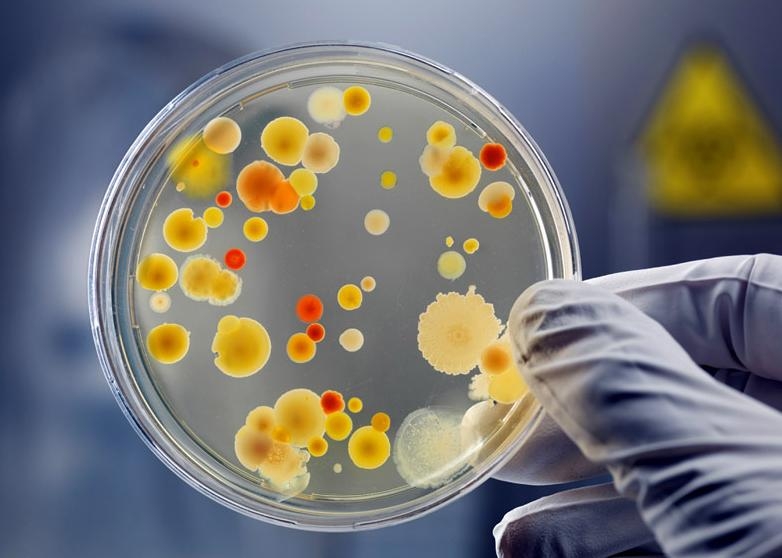
рак

Ученые Университета Данди в Шотландии выяснили, что причиной рака является стареющая иммунная система. Результаты исследования, опубликованные в журнале Proceedings of the National Academy of Sciences, помогут разработать новые методы профилактики и терапии онкологических заболеваний, сообщает MedicalXpress, передает Сегодня.
Вероятность развития злокачественных опухолей резко увеличивается с возрастом. Это объясняется тем, что со временем в ДНК накапливаются дефекты, которые могут привести к перерождению клетки. Считается, для развития рака необходимо пять или шесть мутаций.
Исследователи проанализировали два миллиона случаев заболевания раком среди людей в возрасте от 18 до 70 лет. Затем ученые вывели уравнение, позволяющее рассчитать, как уменьшение активности иммунной системы влияет на возможность формирования опухолей и сравнили теоретические выводы с фактическими данными, включающими 100 видов злокачественных новообразований. Оказалось, что новая модель лучше предсказывает риск рака, чем гипотеза о накоплении мутаций.
Основной причиной старения иммунной системы является дисфункция тимуса (вилочковой железы) – органа, в котором происходит созревание T-клеток. С увеличением возраста человека на каждые 16 лет тимус уменьшается в размере, что приводит к падению производства лимфоцитов, которые распознают опухолевые клетки и уничтожают их. Стимуляция активности вилочковой железы, по мнению ученых, станет эффективным способом для профилактики рака.